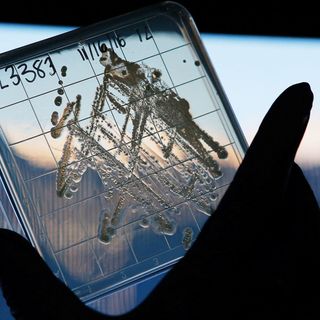

Fossil Fuel Use Causing More Methane Pollution Than We Thought, Scientists Warn
Methane is 80% more powerful at trapping heat in the atmosphere than carbon dioxide.

The burning of fossil fuels produces more methane, a greenhouse gas 80% more powerful than carbon dioxide at trapping heat in the atmosphere, than previously believed, according to new research out of the University of Rochester, U.S.
While scientists already knew human activity contributes to methane emissions, until recently, estimates of how much human activity is responsible compared to other factors, such as the Earth’s natural geologic emissions and emissions from livestock, have been largely (inaccurate) guesswork.
Scientists reached the finding, published in the journal Nature, after analyzing the level of fossil methane gas in ancient air extracted from Greenland’s ice sheet. Methane exists in two forms: fossil methane, which like oil and gas originates deep under the Earth; it escapes to the atmosphere via geological features such as underwater vents and mud volcanoes. The second type of methane is biological methane, which originates from, well, biological sources — livestock gas, wetlands, termites, and landfill decay, for instance.
The samples date from as far back as the 1700s — before humans began burning oil and gas for fuel. Fossil methane was present in very low quantities in these air samples. Three centuries later, however, fossil methane levels in the atmosphere have increased by 150%, suggesting something other than the Earth’s natural geologic activity has contributed to the rise.
That something is the burning of fossil fuels for energy, researchers say, which they estimate contributes 25% to 40% more to atmospheric methane levels than previously believed.
Related on The Swaddle:
India Produces 15% of Global Sulfur Dioxide Emissions, According to Greenpeace Report
The finding, while damning of the oil and gas industry, isn’t as desperate as it seems. Researchers stressed their finding identifies an opportunity to reduce methane emissions — and thus mitigate global warming and climate change — much more rapidly than previously believed possible.
“I don’t want to get too hopeless on this because my data does have a positive implication: most of the methane emissions are anthropogenic, so we have more control. If we can reduce our emissions, it’s going to have more of an impact,” Benjamin Hmiel, PhD, a postdoctoral researcher on the study, said in a statement.
Methane remains in the atmosphere for roughly nine years before it breaks down (into water and carbon dioxide), compared to carbon dioxide, the primary manmade culprit in global warming, which builds up for roughly a century before breaking down. Limiting humans’ methane-producing activities would, therefore, have a much quicker effect on stalling global warming and climate change than regulating carbon dioxide emissions. While the latter is still critical, “if we stopped emitting all carbon dioxide today, high carbon dioxide levels in the atmosphere would still persist for a long time,” Hmiel said in the statement. “Methane is important to study because if we make changes to our current methane emissions, it’s going to reflect more quickly.”
The finding is part of a broader understanding that has emerged in recent years from research that examines greenhouse gases other than carbon dioxide; in November 2019, an international group of scientists warned in an open letter of the global warming effects of nitrogen pollution, which, they said, could create greenhouse gases 300 times more potent than carbon dioxide.
Still, Hmiel and team’s finding is far from the last word on the source of methane emissions. The Washington Post cites other, valid studies that have found geologic sources are contributing more fossil methane to the atmosphere than previously believed. Both findings — that manmade fossil methane, as well as ‘Earth-made’ fossil methane emissions, are higher than we thought — could be true. And perhaps add all the more urgency to Hmiel’s call for more research.
Liesl Goecker is The Swaddle's managing editor.
Related

Why Art, Music Give You Skingasms
